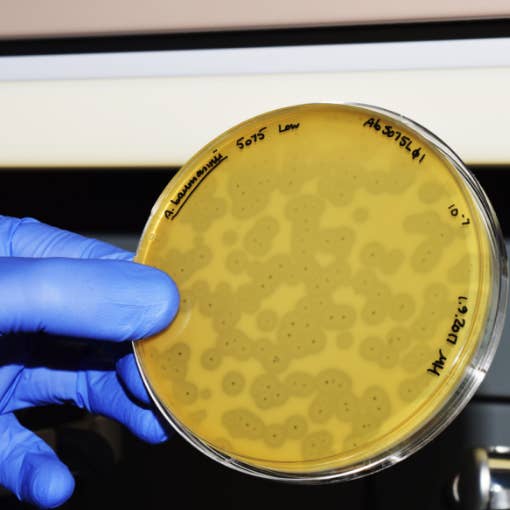
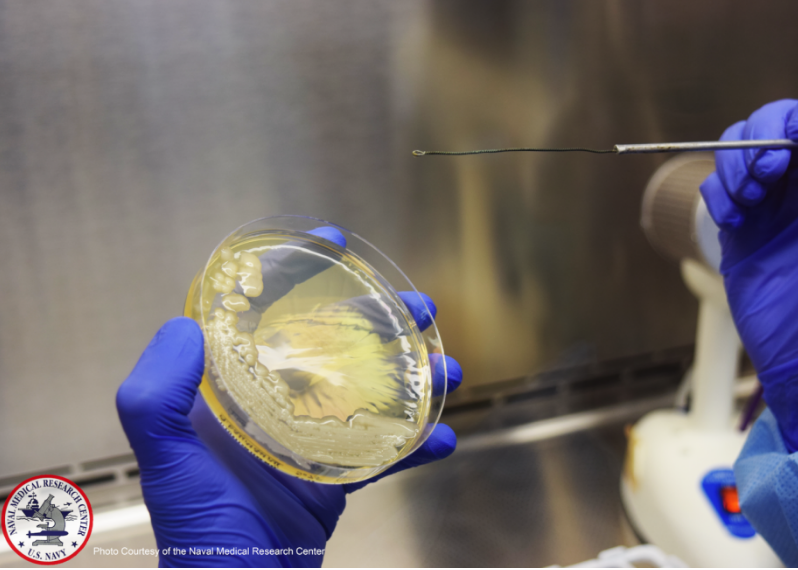
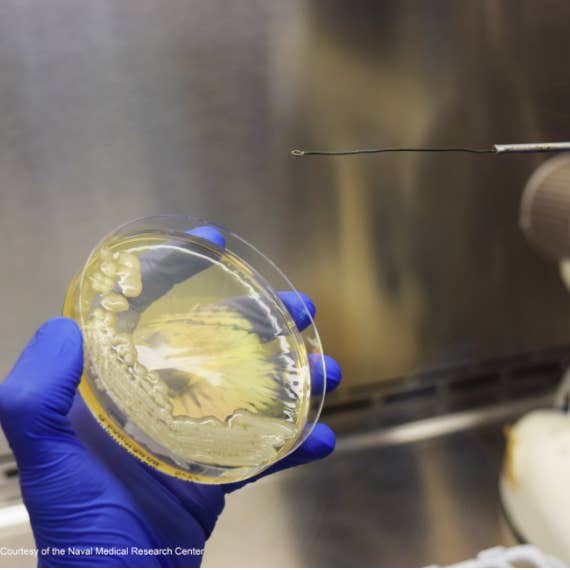

Scientists have long dismissed “phage therapy” as a fringe idea pushed by eccentrics who enjoy fishing in sewage. But now the Navy is betting on it.

Two days subsequent to strolling through the pyramids, Tom Patterson became ill. The psychiatry teacher was in Egypt with his better half on one of their numerous gutsy get-aways far from life in California. One moment he was fine, hamming it up in a touristy stallion and-surrey ride over the abandon. The following, he couldn't quit sweating and regurgitating.
The 300-pound 68-year-old was carried from a facility in Cairo to one in Frankfurt and after that at last back to San Diego, where specialists affirmed an extreme contamination in his guts.
The guilty party was a microscopic organisms called Acinetobacter baumannii, the infamous "Iraqibacter" that developed in military restorative offices amid the Iraq War. It now beat the universal rundown of risky superbugs that don't react to generally anti-infection agents. Some Iraqibacter cases enhance with an exceptionally old, final resort anti-infection called colistin. Be that as it may, it didn't chip away at Tom.
The contamination soon spread to Tom's blood and lungs. For a considerable length of time he was in a San Diego ICU bed in agonizing agony, regularly fantasizing, falling all through a state of extreme lethargy. By late February of 2016, his specialists said they were out of choices.
Tom's significant other, Steffanie Strathdee, is the chief of UC San Diego's Global Health Institute, and one of the world's specialists on how HIV spreads over the world. She profoundly saw how superbugs, left unchecked, would murder a huge number of individuals — including, all of a sudden, her significant other.
Sitting in the healing center room, she swung to Tom. "Nectar, the anti-infection agents aren't working," she said. "I have to know from you on the off chance that you need to continue battling, on the grounds that I would prefer not to keep you alive only for me. Crush my hand on the off chance that you need me to push ahead." He pressed.
Throughout the following seven months, Steffanie went on a momentous medicinal journey, and one that won't not have been conceivable notwithstanding her special position in the more elite class of scholastic science. She accessed exceptionally old treatment — "phage treatment" — in which a patient gets uniquely designed infections to murder their putrefying contamination. Furthermore, she and her partners found these infections, called phages, in a shocking spot: an intensely watched Maryland lab keep running by the US Navy.

Theron Hamilton, head of genomics and bioinformatics at the Biological Defense Research Directorate of the Naval Medical Research Center
This is bizarre, not slightest in light of the fact that standard researchers have since quite a while ago rejected phage treatment as a periphery thought pushed by whimsies who appreciate angling in sewage (where numerous phages live). Be that as it may, in the course of recent years, as an ever increasing number of microscopic organisms have developed approaches to dodge our anti-microbial weapons store, Navy researchers have swung to phages as a last line of resistance. A regular cooler in the Maryland lab holds what's one of the world's biggest phage libraries: more than 300 infections, gathered on ship-based research centers everywhere throughout the world. None of the phages had ever been tried in a tainted individual — until Tom.
"This has never been done anyplace in the nation until this case," said Lieutenant Commander Theron Hamilton, head of genomics and bioinformatics at the Biological Defense Research Directorate of the Naval Medical Research Center. A week ago, his group displayed Tom's case at a phage gathering at the Institute Pasteur in Paris.
In any case, while the researchers in Paris praised the 100-year commemoration of the disclosure of phages, these organic weapons are almost difficult to get to patients in the US. Utilizing nature's own infections to treat contaminations doesn't jive with the FDA's procedure for supporting new pharmaceuticals, nor Big Pharma's rationale to offer one-estimate fits-all pills for the masses.
"Everyone — the FDA and the medicinal group by and large — has been ease back to go out on a limb that would be required to truly draw in completely with a phage therapeutics program," Hamilton said. "I would prefer not to sound excessively dismissive, yet I don't think anyone is anyplace near where the Navy is on this."

Phages attacking a bacterium
The day after her diminishing spouse pressed her hand, Steffanie conversed with an associate whose companion had gotten a comparative anti-toxin safe disease. In a urgent scan for a treatment, this companion of a companion had flown the distance toward the Eastern European nation of Georgia to attempt phage treatment. It had worked.
Steffanie, who has a degree in microbiology, recognized what phages were yet had never caught wind of utilizing them on individuals. In the wake of delving through the papers in English on the treatment, she discovered only a modest bunch of case reports of patients attempting phages in US healing facilities, or who had figured out how to request them from Georgia. In any case, these were remarkable cases.
Phages are the most different and various living things on earth — a great many them coat our skin, live inside our guts, and move through our fixtures. They're totally innocuous to us, yet dangerous to microbes. What's more, not at all like anti-infection agents — which wipe out wide swaths of microscopic organisms, even species that are gainful to us — phages have particular targets. A phage infuses its DNA into its prey, which then reproduces quickly before breaking and executing the cell, discharging considerably more infections to rehash the assault.

"It's the main prescription that develops," Ryland Young, leader of the Center for Phage Technology at Texas A&M University, revealed to BuzzFeed News.
Phage treatment bloomed in Eastern Europe after World War II, to a great extent since scientists there were obstructed from building up the mass-delivered anti-infection agents clearing the West.
"On the off chance that you went to major logical meeting in the US in the 1950s and discussed phage treatment, you'd be giggled out of the room," Young said. "The Eastern Europeans kept it alive in some routes, in light of the fact that in the West we were really fleeing from it."
Right up 'til the present time, centers in Georgia offer phage treatment "mixed drinks" close by anti-toxins as a standard treatment for battling against bacterial diseases.
Then, the 130 distinct anti-infection agents recommended each day in the US are gradually however unquestionably losing the war against microorganisms. Six superbugs specifically, known as the "ESKAPE" pathogens, have developed as the greatest dangers to human wellbeing, tainting no less than 2 million Americans consistently, and murdering no less than 23,000.
Tom's microscopic organisms, Acinetobacter baumannii, is the "An" in "ESKAPE." But Steffanie was resolved not to give her better half a chance to wind up noticeably one of those insights.
Her initially call was to the leader of the irresistible malady unit at UC San Diego, Chip Schooley. "I stated, 'Hello Chip, I believe we're coming up short on alternatives. Shouldn't something be said about phage treatment? I know it sounds a little charm, however I think it might be our lone shot,'" she reviewed.
"It was a radical approach," said Schooley, a virologist whose claim look into includes discovering approaches to execute HIV, hepatitis C, and herpes. "I attempt to dispose of infections, not utilize them to attempt to treat patients."
In any case, he was immediately persuaded that phages were likely Tom's just alternative. He consented to call the FDA and see whether the organization would enable him to give Tom phages as a "sympathetic utilize," which means a test treatment that does not need to keep typical medication controls. In any case, to start with, Steffanie expected to discover somebody who had phages that coordinated Tom's particular contamination.
She discovered Ry Young at Texas A&M, one of only a handful couple of researcher in the US who's attempting to see how phages function. Steffanie sent him a long email about Tom's story, with a photograph of Tom in his doctor's facility bed. Youthful gets these sorts of frantic messages a great deal, and normally gives a conciliatory canned reaction. Yet, when he got notification from Steffanie, he concluded that she was proficient and associated enough that phage treatment could really spare her better half. They wound up chatting on the telephone for two hours, and Young consented to offer assistance.
Steffanie sent Young an example of Tom's superbug, and Young promptly started testing it against the little library of phages his Texas group had amassed. None worked.
"So I did two things: I messaged and called everyone that I knew on the planet that had look into projects with baumannii phages," Young said. He called analysts in India, Australia, and Europe, and at a little organization in San Diego. Inside two or three weeks, he got about 45 phages from around the globe.
At that point he went on what he calls a "decent antiquated phage chase" — gathering tests from sewage plants in Texas and separating almost 100 different phages that may work for Tom.
The FDA, in the interim, returned to Schooley. They let him know they'd given Tom a chance to experience phage treatment, the length of the last item was completely refined. They additionally gave him another contact they thought may be useful: the nation's biggest phage accumulation, at the Navy lab.
For quite a long time, the Navy had just tried its phages in mice. At the point when Hamilton went ahead as the executive in 2015, he was urged to close down the phage explore arm, which he was told was a "money related opening." Instead, he chose to at last test their phages in individuals.
Tom was the ideal initially case. "Somebody's life was remaining in a critical state here," Hamilton said. "I saw no reason not to attempt."
On March 15 of a year ago, Schooley got a FedEx bundle containing styrofoam coolers of sanitized phage mixed drinks from Young's lab, set apart with a "biohazard" sticker. That same day, the FDA formally approved the test treatment. There was no opportunity to lose: Tom's kidneys were coming up short and Steffanie had recently marked his dialysis papers.
"The day the main clump of phages went to Tom's bedside, the lead drug specialist brought them as though he was the ringbearer at the wedding function," Steffanie said. "It was strange taking a gander at this — an illustrious parade or something to that affect."
Schooley pumped those phages through tubes in Tom's stomach, gone for the first site of his contamination. After two days, the Navy's more powerful phages arrived. For these, the specialists utilized a more outrageous approach, infusing the infections straight into Tom's circulation system — a technique that, as far as anyone is concerned, had never been done in the US.
The following day, Tom went into septic stun. "Everyone thought we'd murdered him," Steffanie stated, and they immediately killed the phage implantations. Be that as it may, as it turned out, the stun was brought about by an alternate sort of microscopic organisms. In this way, after two days, they continued the phage treatment. "It was only an exciting ride," she said.
Not long from that point onward, Tom opened his eyes without precedent for weeks, and perceived his little girl remaining by the healing facility bed

After a month, Tom went outside interestingly, in a wheelchair. He had quit utilizing a ventilator, started talking, and played gin rummy with his little girl.
In any case, the fight wasn't over. Around a similar time, the Iraqibacter ended up noticeably impervious to the phages, and Tom's wellbeing started to pointedly decay, once more.
Schooley sent a specimen of the changed microorganisms back to the Navy. Hamilton's group screened their phage library once more, and sent back another, carefully fit mixed drink to assault the new period of Tom's disease.
Everything occurred inside a couple days, which Hamilton sees as one of phage treatment's many points of interest over customary pharmaceuticals. "There's positively no examination," Hamilton said. "It could be years to build up another medication."
In August, nine months after Tom left Egypt, he at long last left the healing facility and went home.
"In my psyche, I was the greatest guinea pig on earth," Tom revealed to BuzzFeed News. He's as yet 100 pounds lighter than when he was first hospitalized, however is at last returning to ordinary life and to his brain science explore at UCSD. "The organization that was beat, the quantity of researchers that went to my guide — they made my survival conceivable."

Tom's case is impelling activity in the Navy's fiscally stale program for phage treatment. Hamilton's group has subsidizing to hereditarily arrangement each of the 300 phages in their library, the initial move towards getting the FDA to endorse a formal clinical trial. Once the specialists screen the phages to ensure they don't contain qualities for poisons or anti-microbial resistance, they will begin huge clinical trials in individuals.
Hamilton trusts the trials, which they're wanting to do this mid year as a team with a privately owned business called Adaptive Phage Therapeutics, will deliver enough information to take the phages to advertise. Despite the fact that the medicines will at first be for the US military, the organization could market them.
Hamilton trusts that the FDA will enable it to sidestep one of the fundamental obstacles now confronting phage treatment in the US: Each hand crafted phage mixed drink would should be affirmed as its own particular medication, a stringent procedure that would make phage treatment everything except incomprehensible, Hamilton said. On the off chance that the FDA rather endorsed the entire library, then specialists could make customized mixed drinks for every patient without requiring endorsement each time.
"On the off chance that each phage is viewed as another medication, there will never be a phage treatment industry," Young said.
In any case, Hamilton recognizes, rolling out this improvement would be an "outlook change" for the FDA, and it still can't seem to freely flag that it's something it would significantly consider. The organization declined to remark for this story.
Cash, as well, hinders conveying phage treatment to the masses. Since phages, similar to anti-infection agents, are taken for brief timeframes and will never be blockbusters like Viagra or Lipitor, couple of pharmaceutical organizations would make the speculation to put up them for sale to the public. Furthermore, since phages can be found in nature, protecting would likewise be troublesome. "On the off chance that an organization puts cash in phages, there's nothing to shield some individual from confining another phage that is near it and doing likewise," Young said. "That is an issue."
The boundaries imply that phage treatment is in all likelihood not going to be the answer for the developing anti-infection agents emergency. In any case, with no new anti-infection agents in the pipeline, this unordinary treatment is one of the main things that may really offer assistance. "I question that will move in the opposite direction of anti-microbials whenever sooner rather than later," David Weiss, chief of the Antibiotic Resistance Center at Emory University School of Medicine, revealed to BuzzFeed News. Be that as it may, he included, "conventional anti-microbial treatment and phages may in principle be utilized together."
Steffanie will be a coauthor, alongside Hamilton, Schooley, and Young, on an anticipated logical paper about Tom's phage treatment experience, and she and Tom are taking a shot at a book.
"Phage treatment as a field sort of slammed into our lives in this supernaturally strange way," she said. "Each time I take a gander at him now I simply imagine that consistently is a blessing." ●

No comments:
Post a Comment